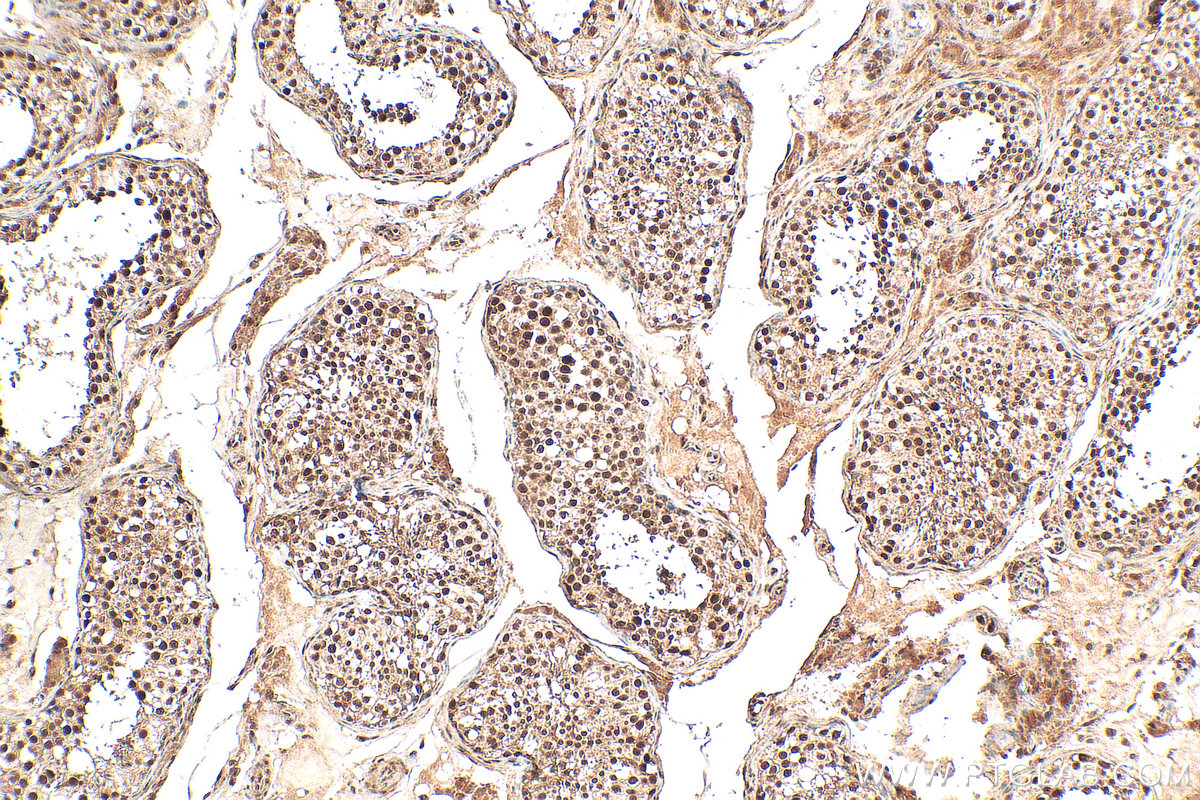
IHC staining of human testis using 21183-1-AP (same clone as 21183-1-PBS)
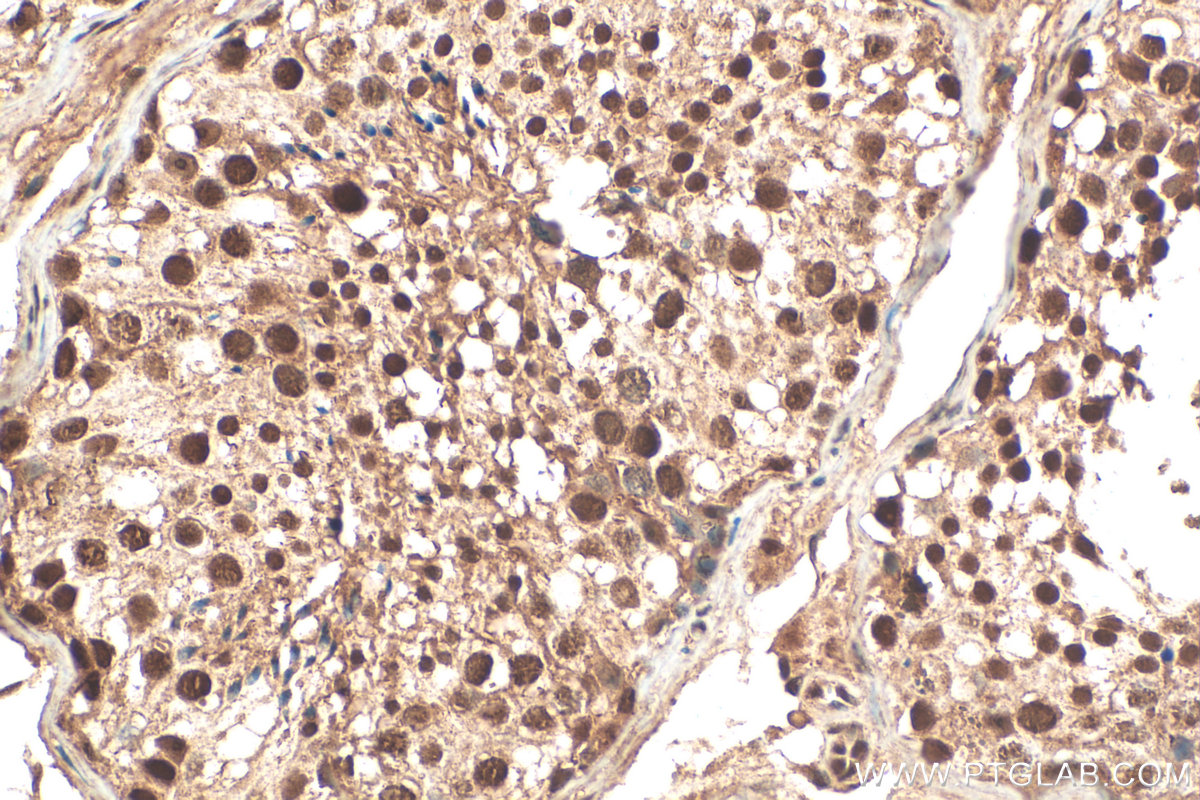
IHC staining of human testis using 21183-1-AP (same clone as 21183-1-PBS)

验证数据展示
产品信息
21183-1-PBS targets C13orf18 in WB, IHC, IF/ICC, Indirect ELISA applications and shows reactivity with human samples.
| 经测试应用 | WB, IHC, IF/ICC, Indirect ELISA Application Description |
| 经测试反应性 | human |
| 免疫原 |
CatNo: Ag15474 Product name: Recombinant human C13orf18 protein Source: e coli.-derived, PKG Tag: GST Domain: 1-306 aa of BC032311 Sequence: MVSQSTVRQDSPVEPWEGISDHSGIIDGSPRLLNTDHPPCQLDIRLMRHKAVWINPQDVQQQPQDLQSQVPAAGNSGTHFVTDAASPSGPSPSCLGDSLAETTLSEDTTDSVGSASPHGSSEKSSSFSLSSTEVHMVRPGYSHRVSLPTSPGILATSPYPETDSAFFEPSHLTSAADEGAVQVSRRTISSNSFSPEVFVLPVDVEKENAHFYVADMIISAMEKMKCNILSQQQTESWSKEVSGLLGSDQPDSEMTFDTNIKQESGSSTSSYSGYEGCAVLQVSPVTETRTYHDVKEICKCDVDEFV 种属同源性预测 |
| 宿主/亚型 | Rabbit / IgG |
| 抗体类别 | Polyclonal |
| 产品类型 | Antibody |
| 全称 | chromosome 13 open reading frame 18 |
| 别名 | Pacer, Protein associated with UVRAG as autophagy enhancer, Protein Rubicon-like, RUBCNL |
| 计算分子量 | 662 aa, 73 kDa |
| 观测分子量 | 66 kDa |
| GenBank蛋白编号 | BC032311 |
| 基因名称 | C13orf18 |
| Gene ID (NCBI) | 80183 |
| RRID | AB_10733098 |
| 偶联类型 | Unconjugated |
| 形式 | Liquid |
| 纯化方式 | Antigen affinity purification |
| UNIPROT ID | Q9H714 |
| 储存缓冲液 | PBS only, pH 7.3. |
| 储存条件 | Store at -80°C. The product is shipped with ice packs. Upon receipt, store it immediately at -80°C |
背景介绍
C13orf18 (also known as Pacer), now formally designated RUBCNL (Rubicon-like autophagy enhancer), is a protein containing an EF-hand calcium-binding domain with potential transporter functions. Initially identified as a candidate tumor suppressor gene, it is frequently silenced in cervical cancer due to promoter hypermethylation. Its re-expression inhibits cervical cancer cell proliferation, suggesting tumor-suppressing activity. Furthermore, research has revealed that polymorphisms in the 3'UTR region of the C13orf18 gene are associated with amyotrophic lateral sclerosis (ALS), suggesting its potential involvement in autophagy regulation and the pathogenesis of neurodegenerative diseases.